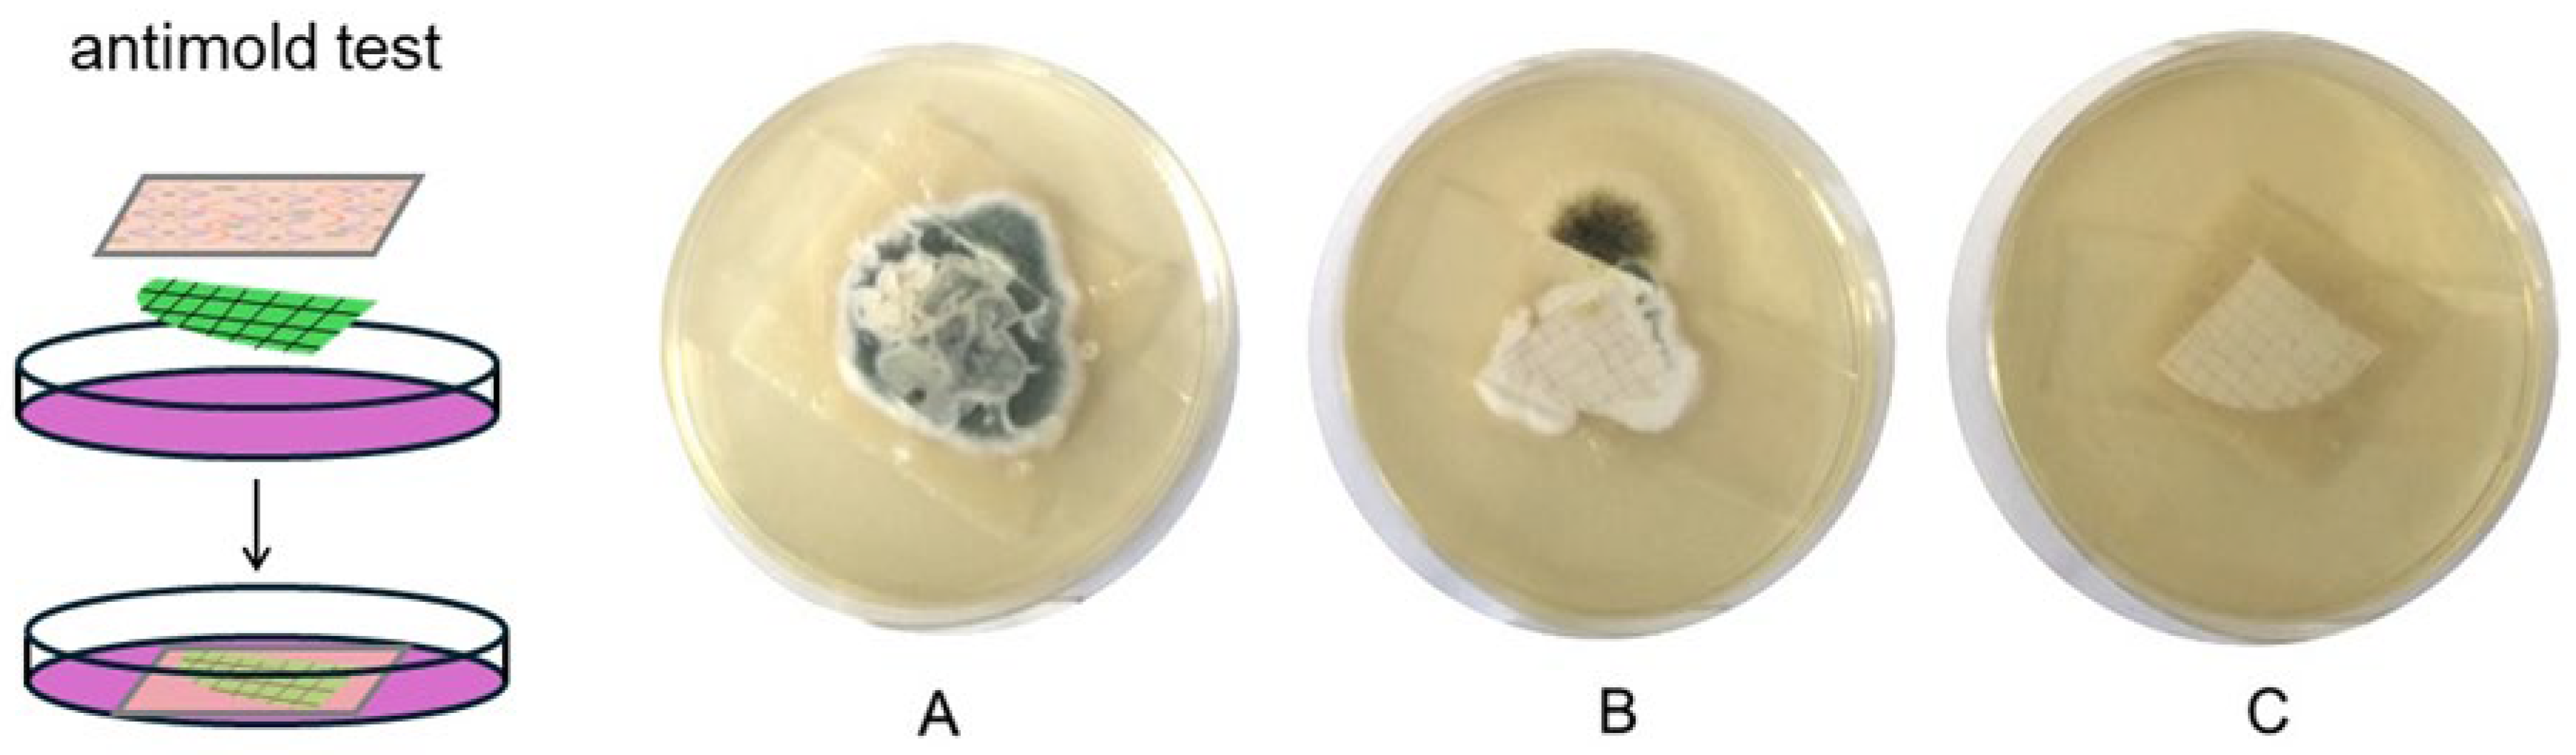
Molecules 30 02257 g005

Active Pectin/Carboxymethylcellulose Composite Films for Bread Packaging
Abstract
1. Introduction
2. Results and Discussion
2.1. Film Formulation
2.2. Functional Properties of PEC/CMC Self-Standing Films
2.2.1. Mechanical Properties
2.2.2. Barrier Properties
2.2.3. Morphological Characterization
2.2.4. Antimold Activity
2.2.5. Release of Active Species to Bread
2.2.6. Further Characterization in View of Use as Films for Packaging
2.3. Functional Properties of PEC/CMC Film-Forming Solutions Used as Coatings
3. Materials and Methods
3.1. Materials
3.2. Methods
3.2.1. Experimental Preparations
- (a)
- Ca2+ salts: Calcium chloride (CaCl2), calcium acetate monohydrate (CaA), or calcium propionate (CaP) were used as crosslinkers. A total of 1.9 mmol was dissolved in 25 mL of water and added to the PEC/CMC solution under vigorous stirring at 75 °C. After 30 min of stirring, the solution was allowed to cool at RT.
- (b)
- AgZ or plain Z in a 10% w/w proportion with respect to PEC was suspended in 1 mL of water and added at RT.
3.2.2. Characterization of PEC/CMC Films
- -
- A total of 30 slices of bread (3 × 3 cm2 each) were packed in common LDPE film closed with a heat sealer.
- -
- A total of 30 slices of bread (3 × 3 cm2 each) were packed and sealed in a CaP film and then further packed in an external LDPE bag.
- -
- A total of 30 slices of bread (3 × 3 cm2) were packed in a CaP + AgZ film and then further packed in an external LDPE bag. All the bags were maintained in the dark at a controlled temperature (25 °C), and visual evaluation of the presence of molds was conducted twice a day. The shelf life experiment was repeated three times.
3.3. Characterization of the Film-Forming Solutions
3.4. Statistical Analysis
4. Conclusions
5. Patents
Supplementary Materials
Author Contributions
Funding
Institutional Review Board Statement
Informed Consent Statement
Data Availability Statement
Acknowledgments
Conflicts of Interest
References
- European Union Regulation (EU). 2025/40 of the European Parliament of the Council of 17 January 2025 on packaging and packaging waste. Off. J. Eur. Union. 2025, L40, 22–42. [Google Scholar]
- European Commission. Strategy for Plastics in a Circular Economy; European Commission: Brussels, Belgium, 2018; Volume 30, pp. 577–580. [Google Scholar]
- Nechita, P.; Roman, M. Review on Polysaccharides Used in Coatings for Food Packaging Papers. Coatings 2020, 10, 566. [Google Scholar] [CrossRef]
- Kumar, N.; Neeraj. Polysaccharide-based component and their relevance in edible film/coating: A review. Nutr. Food Sci. 2019, 49, 793–823. [Google Scholar] [CrossRef]
- Garavand, F.; Rouhi, M.; Razavi, S.H.; Cacciotti, I.; Mohammadi, R. Improving the integrity of natural biopolymer films used in food packaging by crosslinking approach: A review. Int. J. Biol. Macromol. 2017, 104, 687–707. [Google Scholar] [CrossRef]
- Kunam, P.K.; Ramakanth, D.; Akhila, K.; Gaikwad, K.K. Bio-based materials for barrier coatings on paper packaging. Biomass Convers. Biorefinery 2022, 14, 12637–12652. [Google Scholar] [CrossRef]
- Ureña, M.; Phùng, T.T.-T.; Gerometta, M.; de Siqueira Oliveira, L.; Chanut, J.; Domenek, S.; Dole, P.; Roudaut, G.; Lagorce, A.; Karbowiak, T. Potential of polysaccharides for food packaging applications. Part 1/2: An experimental review of the functional properties of polysaccharide coatings. Food Hydrocoll. 2023, 144, 108955. [Google Scholar] [CrossRef]
- Cauvain, S.P. Bread Making; Woodhead Publishing Limited: Cambridge, UK, 2003; ISBN 978-1-85573-553-8. [Google Scholar]
- Melini, V.; Melini, F. Strategies to Extend Bread and GF Bread Shelf-Life: From Sourdough to Antimicrobial Active Packaging and Nanotechnology. Fermentation 2018, 4, 9. [Google Scholar] [CrossRef]
- Axel, C.; Zannini, E.; Arendt, E.K. Mold spoilage of bread and its biopreservation: A review of current strategies for bread shelf life extension. Crit. Rev. Food Sci. Nutr. 2017, 57, 3528–3542. [Google Scholar] [CrossRef]
- European Parliament and the Concil of the European Union Regulation (EC). No 1333/2008 of the European Parliament ans of the Council of 16 December 2998 on food additives. Off. J. Eur. Union. 2008, L354, 16–33. [Google Scholar]
- Dao, T.; Dantigny, P. Control of food spoilage fungi by ethanol. Food Control 2011, 22, 360–368. [Google Scholar] [CrossRef]
- Levinskaite, L. Susceptibility of food-contaminating Penicillium genus fungi to some preservatives and disinfectants. Ann. Agric. Environ. Med. 2012, 19, 85–89. [Google Scholar]
- Pasqualone, A. Bread Packaging: Features and Functions. In Flour and Breads and their Fortification in Health and Disease Prevention; Academic Press: Cambridge, MA, USA, 2019; pp. 211–222. ISBN 9780128146392. [Google Scholar]
- European Commision Commission Regulation (EC). No 450/2009 of on active and intelligent materials and articles intended to come into contact with food. Off. J. Eur. Union. 2009, L135, 3–11. [Google Scholar]
- Jideani, V.A.; Vogt, K. Antimicrobial Packaging for Extending the Shelf Life of Bread—A Review. Crit. Rev. Food Sci. Nutr. 2016, 56, 1313–1324. [Google Scholar] [CrossRef]
- Zhao, Y.; An, J.; Su, H.; Li, B.; Liang, D.; Huang, C. Antimicrobial food packaging integrating polysaccharide-based substrates with green antimicrobial agents: A sustainable path. Food Res. Int. 2022, 155, 111096. [Google Scholar] [CrossRef]
- Noshirvani, N.; Ghanbarzadeh, B.; Rezaei Mokarram, R.; Hashemi, M. Novel active packaging based on carboxymethyl cellulose-chitosan-ZnO NPs nanocomposite for increasing the shelf life of bread. Food Packag. Shelf Life 2017, 11, 106–114. [Google Scholar] [CrossRef]
- Istiqola, A.; Syafiuddin, A. A review of silver nanoparticles in food packaging technologies: Regulation, methods, properties, migration, and future challenges. J. Chin. Chem. Soc. 2020, 67, 1942–1956. [Google Scholar] [CrossRef]
- Adeyemi, J.O.; Fawole, O.A. Metal-Based Nanoparticles in Food Packaging and Coating Technologies: A Review. Biomolecules 2023, 13, 1092. [Google Scholar] [CrossRef]
- Couto, C.; Almeida, A. Metallic Nanoparticles in the Food Sector: A Mini-Review. Foods 2022, 11, 402. [Google Scholar] [CrossRef]
- Pallavicini, P.; Taglietti, A.; Dacarro, G.; Antonio Diaz-Fernandez, Y.; Galli, M.; Grisoli, P.; Patrini, M.; Santucci De Magistris, G.; Zanoni, R. Self-assembled monolayers of silver nanoparticles firmly grafted on glass surfaces: Low Ag+ release for an efficient antibacterial activity. J. Colloid. Interface Sci. 2010, 350, 110–116. [Google Scholar] [CrossRef]
- European Commision Commission Regulation (EU). No 10/2011 of 14 January 2011. Off. J. Eur. Union. 2011, L10, 1–89. [Google Scholar]
- European Commision Commission Regulation (EU). 2016/1416 of 24 August 2016 amending and correcting Regulation (EU) No 10/2011 on plastic materials and articles intended to come into contact with food. Off. J. Eur. Union. 2016, L230, 22–42. [Google Scholar]
- Šešlija, S.; Nešić, A.; Škorić, M.L.; Krušić, M.K.; Santagata, G.; Malinconico, M. Pectin/Carboxymethylcellulose Films as a Potential Food Packaging Material. Macromol. Symp. 2018, 378, 1600163. [Google Scholar] [CrossRef]
- Phùng, T.-T.-T.; Gerometta, M.; Chanut, J.; Raise, A.; Ureña, M.; Dupont, S.; Beney, L.; Karbowiak, T. Comprehensive approach to the protection and controlled release of extremely oxygen sensitive probiotics using edible polysaccharide-based coatings. Int. J. Biol. Macromol. 2022, 218, 706–719. [Google Scholar] [CrossRef]
- Yu, W.-X.; Wang, Z.-W.; Hu, C.-Y.; Wang, L. Properties of low methoxyl pectin-carboxymethyl cellulose based on montmorillonite nanocomposite films. Int. J. Food Sci. Technol. 2014, 49, 2592–2601. [Google Scholar] [CrossRef]
- Yaradoddi, J.S.; Banapurmath, N.R.; Ganachari, S.V.; Soudagar, M.E.M.; Mubarak, N.M.; Hallad, S.; Hugar, S.; Fayaz, H. Biodegradable carboxymethyl cellulose based material for sustainable packaging application. Sci. Rep. 2020, 10, 21960. [Google Scholar] [CrossRef]
- Roy, S.; Rhim, J. Carboxymethyl cellulose-based antioxidant and antimicrobial active packaging film incorporated with curcumin and zinc oxide. Int. J. Biol. Macromol. 2020, 148, 666–676. [Google Scholar] [CrossRef]
- Peighambardoust, S.J.; Zahed-Karkaj, S.; Peighambardoust, S.H.; Ebrahimi, Y.; Peressini, D. Characterization of carboxymethyl cellulose-based active films incorporating non-modified and Ag or Cu-modified Cloisite 30B and montmorillonite nanoclays. Iran. Polym. J. 2020, 29, 1087–1097. [Google Scholar] [CrossRef]
- Ren, W.; Qiang, T.; Chen, L. Recyclable and biodegradable pectin-based film with high mechanical strength. Food Hydrocoll. 2022, 129, 107643. [Google Scholar] [CrossRef]
- Mellinas, C.; Ramos, M.; Jiménez, A.; Garrigós, M.C. Recent Trends in the Use of Pectin from Agro-Waste Residues as a Natural-Based Biopolymer for Food Packaging Applications. Materials 2020, 13, 673. [Google Scholar] [CrossRef]
- Ureña, M.; Fournier, P.; Phùng, T.T.-T.; Lagorce, A.; Karbowiak, T. Potential of polysaccharides for food packaging applications. Part 2/2: An experimental review of the effect of aging conditions on the functional properties of polysaccharide films. Food Hydrocoll. 2023, 144, 108954. [Google Scholar] [CrossRef]
- Vlacha, M.; Giannakas, A.; Katapodis, P.; Stamatis, H.; Ladavos, A.; Barkoula, N.-M. On the efficiency of oleic acid as plasticizer of chitosan/clay nanocomposites and its role on thermo-mechanical, barrier and antimicrobial properties—Comparison with glycerol. Food Hydrocoll. 2016, 57, 10–19. [Google Scholar] [CrossRef]
- da Silva, M.A.; Bierhalz, A.C.K.; Kieckbusch, T.G. Alginate and pectin composite films crosslinked with Ca2+ ions: Effect of the plasticizer concentration. Carbohydr. Polym. 2009, 77, 736–742. [Google Scholar] [CrossRef]
- Villa, C.C.; Valencia, G.A.; López Córdoba, A.; Ortega-Toro, R.; Ahmed, S.; Gutiérrez, T.J. Zeolites for food applications: A review. Food Biosci. 2022, 46, 101577. [Google Scholar] [CrossRef]
- Youssef, H.F.; El-Naggar, M.E.; Fouda, F.K.; Youssef, A.M. Antimicrobial packaging film based on biodegradable CMC/PVA-zeolite doped with noble metal cations. Food Packag. Shelf Life 2019, 22, 100378. [Google Scholar] [CrossRef]
- Fernández, A.; Soriano, E.; Hernández-Muñoz, P.; Gavara, R. Migration of Antimicrobial Silver from Composites of Polylactide with Silver Zeolites. J. Food Sci. 2010, 75, E186–E193. [Google Scholar] [CrossRef]
- EFSA Panel on Food Contact Materials, Enzymes, Flavourings and Processing Aids (CEF). Scientific Opinion on the safety evaluation of the substance silver zeolite A (silver zinc sodium ammonium alumino silicate), silver content 2–5%, for use in food contact materials. EFSA J. 2011, 9, 1999. [Google Scholar] [CrossRef]
- Jafarzadeh, S.; Jafari, S.M. Impact of metal nanoparticles on the mechanical, barrier, optical and thermal properties of biodegradable food packaging materials. Crit. Rev. Food Sci. Nutr. 2021, 61, 2640–2658. [Google Scholar] [CrossRef]
- Robertson, G.L. Legislative and Safety Aspects of Food Packaging. In Food Packaging; CRC Press: Boca Raton, FL, USA, 2016; pp. 637–674. ISBN 9781439862421. [Google Scholar]
- Giacinti Baschetti, M.; Minelli, M. Test methods for the characterization of gas and vapor permeability in polymers for food packaging application: A review. Polym. Test. 2020, 89, 106606. [Google Scholar] [CrossRef]
- Ngo, T.M.P.; Nguyen, T.H.; Dang, T.M.Q.; Tran, T.X.; Rachtanapun, P. Characteristics and antimicrobial properties of active edible films based on pectin and nanochitosan. Int. J. Mol. Sci. 2020, 21, 2224. [Google Scholar] [CrossRef]
- Wang, Q.; Chen, W.; Zhu, W.; McClements, D.J.; Liu, X.; Liu, F. A review of multilayer and composite films and coatings for active biodegradable packaging. Npj Sci. Food 2022, 6, 18. [Google Scholar] [CrossRef]
- Wu, F.; Misra, M.; Mohanty, A.K. Challenges and new opportunities on barrier performance of biodegradable polymers for sustainable packaging. Prog. Polym. Sci. 2021, 117, 101395. [Google Scholar] [CrossRef]
- Long, J.; Zhang, W.; Zhao, M.; Ruan, C.Q. The reduce of water vapor permeability of polysaccharide-based films in food packaging: A comprehensive review. Carbohydr. Polym. 2023, 321, 121267. [Google Scholar] [CrossRef]
- Dharini, V.; Periyar Selvam, S.; Jayaramudu, J.; Sadiku Emmanuel, R. Functional properties of clay nanofillers used in the biopolymer-based composite films for active food packaging applications-Review. Appl. Clay Sci. 2022, 226, 106555. [Google Scholar] [CrossRef]
- Sadegh-Hassani, F.; Mohammadi Nafchi, A. Preparation and characterization of bionanocomposite films based on potato starch/halloysite nanoclay. Int. J. Biol. Macromol. 2014, 67, 458–462. [Google Scholar] [CrossRef]
- Yang, X.; Nisar, T.; Liang, D.; Hou, Y.; Sun, L.; Guo, Y. Low methoxyl pectin gelation under alkaline conditions and its rheological properties: Using NaOH as a pH regulator. Food Hydrocoll. 2018, 79, 560–571. [Google Scholar] [CrossRef]
- Lopez, C.G.; Richtering, W. Oscillatory rheology of carboxymethyl cellulose gels: Influence of concentration and pH. Carbohydr. Polym. 2021, 267, 118117. [Google Scholar] [CrossRef]
- Russo, R.; Malinconico, M.; Santagata, G. Effect of Cross-Linking with Calcium Ions on the Physical Properties of Alginate Films. Biomacromolecules 2007, 8, 3193–3197. [Google Scholar] [CrossRef]
- Dacarro, C.; Grisoli, P.; Del Frate, G.; Villani, S.; Grignani, E.; Cottica, D. Micro-organisms and dust exposure in an Italian grain mill. J. Appl. Microbiol. 2005, 98, 163–171. [Google Scholar] [CrossRef]
- Varga, J.; Kocsubé, S.; Tóth, B.; Frisvad, J.C.; Perrone, G.; Susca, A.; Meijer, M.; Samson, R.A. Aspergillus brasiliensis sp. nov., a biseriate black Aspergillus species with world-wide distribution. Int. J. Syst. Evol. Microbiol. 2007, 57, 1925–1932. [Google Scholar] [CrossRef]
- Perugini, P.; Bonetti, M.; Guerini, M.; Musitelli, G.; Grisoli, P. A New In Vitro Model to Evaluate Anti-Adhesive Effect against Fungal Nail Infections. Appl. Sci. 2021, 11, 1977. [Google Scholar] [CrossRef]
- Phechkrajang, C.M.; Yooyong, S. Fast and simple method for semiquantitative determination of calcium propionate in bread samples. J. Food Drug Anal. 2017, 25, 254–259. [Google Scholar] [CrossRef] [PubMed]
- Guzman-Puyol, S.; Benítez, J.J.; Heredia-Guerrero, J.A. Transparency of polymeric food packaging materials. Food Res. Int. 2022, 161, 111792. [Google Scholar] [CrossRef]
- Intawiwat, N.; Myhre, E.; Øysaed, H.; Jamtvedt, S.H.; Pettersen, M.K. Packaging materials with tailor made light transmission properties for food protection. Polym. Eng. Sci. 2012, 52, 2015–2024. [Google Scholar] [CrossRef]
- Kowalonek, J.; Kaczmarek, H. Studies of pectin/polyvinylpyrrolidone blends exposed to ultraviolet radiation. Eur. Polym. J. 2010, 46, 345–353. [Google Scholar] [CrossRef]
- Fluidan Automate Viscosity Control in Manifacture of Paint. Available online: https://fluidan.com/manufacturing-of-paint/ (accessed on 12 May 2025).
- Mierczyńska, J.; Cybulska, J.; Sołowiej, B.; Zdunek, A. Effect of Ca2+, Fe2+ and Mg2+ on rheological properties of new food matrix made of modified cell wall polysaccharides from apple. Carbohydr. Polym. 2015, 133, 547–555. [Google Scholar] [CrossRef]
- Cheng, D.C.-H. Thixotropy. Int. J. Cosmet. Sci. 1987, 9, 151–191. [Google Scholar] [CrossRef]
- Mewis, J.; Wagner, N.J. Thixotropy. Adv. Colloid. Interface Sci. 2009, 147–148, 214–227. [Google Scholar] [CrossRef]
- ASTM E96-E96M:2016; Standard Test Method for Water Vapor Transmission of Materials. Annual Book of ASTM Standards. American Society for Testing and Materials: Philadelphia, PA, USA, 2016.
- Grisoli, P.; De Vita, L.; Milanese, C.; Taglietti, A.; Diaz Fernandez, Y.; Bouzin, M.; D’Alfonso, L.; Sironi, L.; Rossi, S.; Vigani, B.; et al. PVA Films with Mixed Silver Nanoparticles and Gold Nanostars for Intrinsic and Photothermal Antibacterial Action. Nanomaterials 2021, 11, 1387. [Google Scholar] [CrossRef]

| Films | Thickness (µm) | Young’s Modulus (GPa) | Tensile Strength (MPa) | Elongation at Break (%) |
|---|---|---|---|---|
| MB | 12.6(±0.5) a | 0.80(±0.03) c,d | 26(±1) b,c | 198(±28) c |
| LDPE | 51(±1) c,d | 0.26(±0.03) a | 18(±2) a | 1206(±121) d |
| PEC/CMC/OA | 47(±2) b,c,d | 1.35(±0.09) e | 35(±5) b,c,d | 2.6(±7) a |
| PEC/CMC/OA/CaCl2 | 54(±7) d | 0.56(±0.05) b | 51(±7) b,c,d | 7(±1) b |
| PEC/CMC/OA/CaA | 65(±7) e | 0.75(±0.07) b,c,d | 59(±15) c,d | 8(±1) b |
| PEC/CMC/OA/CaA/Z | 64(±7) e | 0.69(±0.05) b,c,d | 55(±16) c,d | 8(±1) b |
| PEC/CMC/OA/CaA/AgZ | 47(±5) b,c,d | 0.60(±0.01) b,c | 54(±11) b,c,d | 8(±1) b |
| PEC/CMC/OA/CaP | 43(±4) b,c | 0.85(±0.06) d | 63(±15) d | 8(±2) b |
| PEC/CMC/OA/CaP/Z | 40(±5) b | 0.70(±0.01) b,c,d | 50(±16) b,c,d | 9(±3) b |
| PEC/CMC/OA/CaP/AgZ | 50(±4) c,d | 0.60(±0.01) b,c | 54(±11) b,c,d | 8(±1) b |
| Film-Forming Solutions | pH |
|---|---|
| PEC/CMC/OA | 3.89(±4) b |
| PEC/CMC/OA/CaCl2 | 3.50(±1) a |
| PEC/CMC/OA/CaA | 4.40(±8) c |
| PEC/CMC/OA/CaA Z | 5.00(±2) d |
| PEC/CMC/OA/CaP | 4.80(±3) d |
| PEC/CMC/OA/CaP Z | 5.71(±7) e |
| Fungal Strain | PEC/CMC/OA/CaP | PEC/CMC/OA/CaP/AgZ |
|---|---|---|
| ME | ME | |
| Aspergillus niger | 3.36 (±0.34) | 3.64 (0.23) |
| Penicillium janthinellum | 2.7 (0.42) | 4.71 (0.44) |
| Penicillium supp. Wild type | 2.1 (0.56) | 3.94 (0.62) |
| Days of Contact | B: Small Samples, 5 g of Bread | C: Piled Samples, 30 g of Bread |
|---|---|---|
| mg Ag/kg Bread | mg Ag/kg Bread | |
| 1 | 0.05(±0.01) | 0.043(±0.004) |
| 3 | 0.06(±0.02) | 0.030(±0.005) |
| 7 | 0.05(±0.01) | 0.03(±0.01) |
| Film-Forming Solutions | Ostwald de Waele Model Fitting Parameters | Thixotropy (ΔA Pa/s) | ||
|---|---|---|---|---|
| K | N | R2 | ||
| PEC/CMC/OA | 2.01(±7) a | 0.744(±4) d | 0.99(±1) | 566(±45) a |
| PEC/CMC/OA/CaCl2 | 20(±2) b | 0.45(±2) c | 0.9991(±3) | 3780(±1221) b |
| PEC/CMC/OA/CaA | 31(±3) c | 0.44(±1) b,c | 0.9988(±5) | 3812(±691) b |
| PEC/CMC/OA/CaA/Z | 57(±3) e | 0.308(±7) a | 0.996(±2) | 5878(±488) c |
| PEC/CMC/OA/CaP | 40(±1) d | 0.422(±4) b | 0.9989(±2) | 4595(±294) b,c |
| PEC/CMC/OA/CaP/Z | 35.1(±6) c | 0.413(±2) b | 0.9992(±5) | 3993(±232) b |
Disclaimer/Publisher’s Note: The statements, opinions and data contained in all publications are solely those of the individual author(s) and contributor(s) and not of MDPI and/or the editor(s). MDPI and/or the editor(s) disclaim responsibility for any injury to people or property resulting from any ideas, methods, instructions or products referred to in the content. |
© 2025 by the authors. Licensee MDPI, Basel, Switzerland. This article is an open access article distributed under the terms and conditions of the Creative Commons Attribution (CC BY) license (https://creativecommons.org/licenses/by/4.0/).
Share and Cite
Doveri, L.; Diaz Fernandez, Y.A.; Dacarro, G.; Grisoli, P.; Milanese, C.; Urena, M.; Sok, N.; Karbowiak, T.; Pallavicini, P. Active Pectin/Carboxymethylcellulose Composite Films for Bread Packaging. Molecules 2025, 30, 2257. https://doi.org/10.3390/molecules30112257
Doveri L, Diaz Fernandez YA, Dacarro G, Grisoli P, Milanese C, Urena M, Sok N, Karbowiak T, Pallavicini P. Active Pectin/Carboxymethylcellulose Composite Films for Bread Packaging. Molecules. 2025; 30(11):2257. https://doi.org/10.3390/molecules30112257
Chicago/Turabian StyleDoveri, Lavinia, Yuri Antonio Diaz Fernandez, Giacomo Dacarro, Pietro Grisoli, Chiara Milanese, Maria Urena, Nicolas Sok, Thomas Karbowiak, and Piersandro Pallavicini. 2025. "Active Pectin/Carboxymethylcellulose Composite Films for Bread Packaging" Molecules 30, no. 11: 2257. https://doi.org/10.3390/molecules30112257
APA StyleDoveri, L., Diaz Fernandez, Y. A., Dacarro, G., Grisoli, P., Milanese, C., Urena, M., Sok, N., Karbowiak, T., & Pallavicini, P. (2025). Active Pectin/Carboxymethylcellulose Composite Films for Bread Packaging. Molecules, 30(11), 2257. https://doi.org/10.3390/molecules30112257

